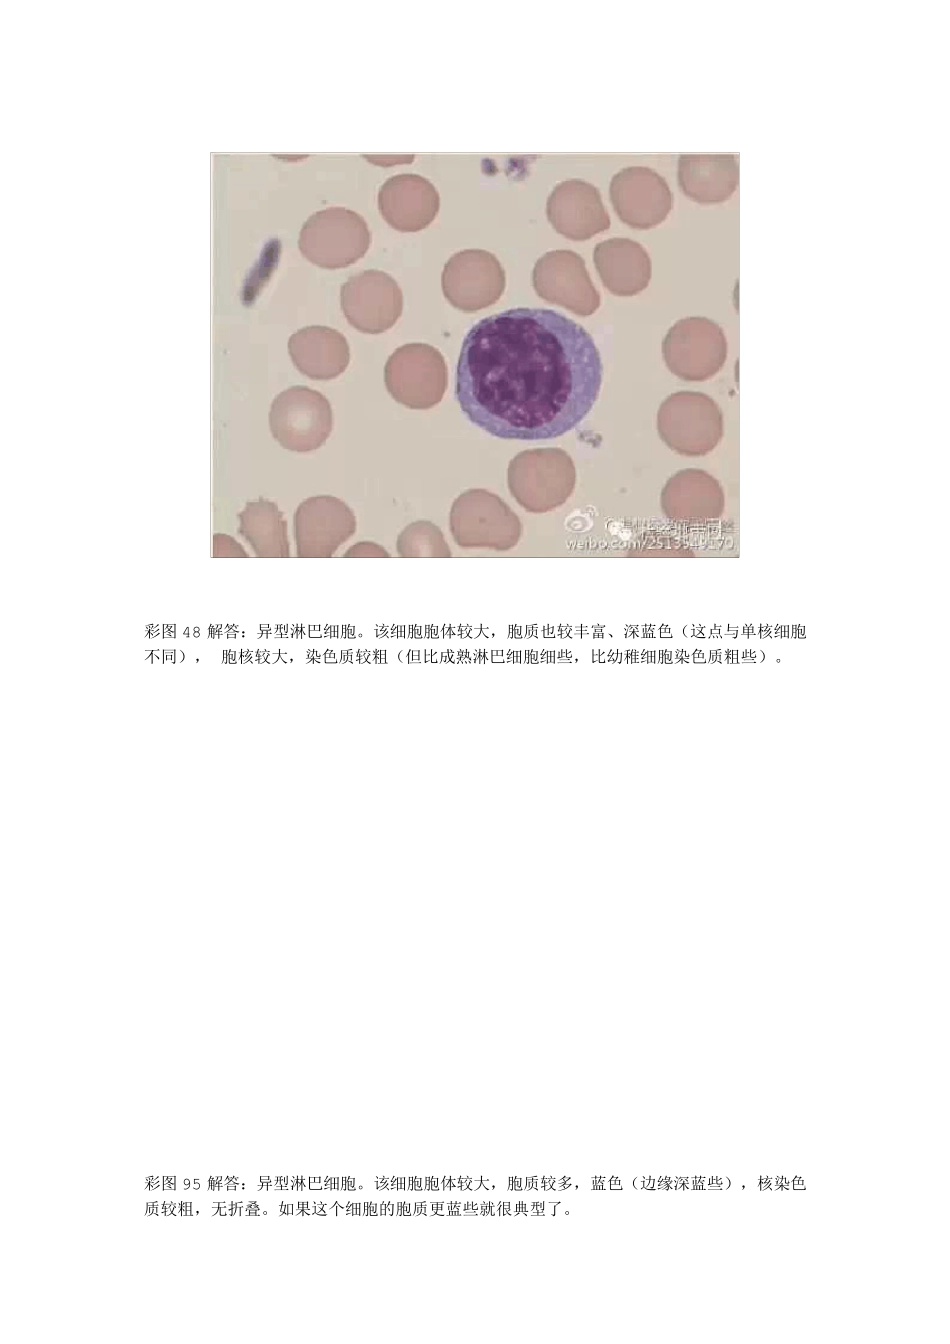
异型淋巴细胞的鉴定与区别_第2页
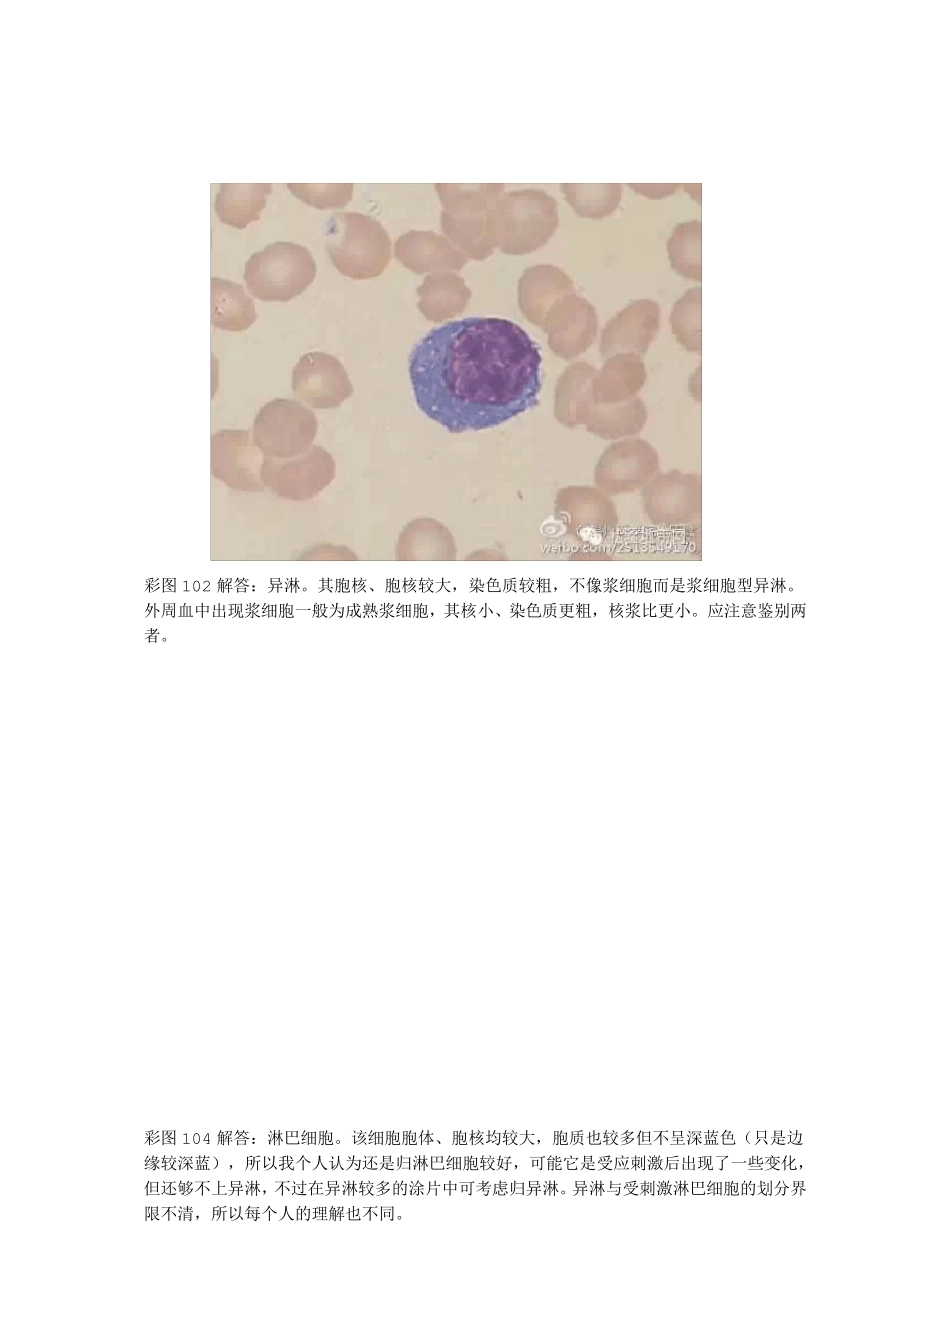
异型淋巴细胞的鉴定与区别_第3页

彩图1 解答:淋巴细胞(左),异型淋巴细胞(右)
左边细胞胞质呈淡蓝色(略带灰)而没有中性颗粒,胞体也不大
右边细胞的胞体大、胞质较深蓝且较多、染色质较粗,这些都是异淋的特点
而早幼红细胞胞核圆形、染色质较细,核常居中,血片出现早幼红细胞的概率远远低于异淋
彩图17 解答:异型淋巴细胞(左)和嗜酸性分叶核粒细胞(右,分 2 叶)
异型淋巴细胞胞核凹陷,染色质较粗,胞质较多且蓝色
嗜酸性粒细胞可见颗粒减少,但嗜酸性颗粒颜色较典型
彩图48 解答:异型淋巴细胞
该细胞胞体较大,胞质也较丰富、深蓝色(这点与单核细胞不同), 胞核较大,染色质较粗(但比成熟淋巴细胞细些,比幼稚细胞染色质粗些)
彩图95 解答:异型淋巴细胞
该细胞胞体较大,胞质较多,蓝色(边缘深蓝些),核染色质较粗,无折叠
如果这个细胞的胞质更蓝些就很典型了
彩图102 解答:异淋
其胞核、胞核较大,染色质较粗,不像浆细胞而是浆细胞型异淋
外周血中出现浆细胞一般为成熟浆细胞,其核小、染色质更粗,核浆比更小
应注意鉴别两者
彩图104 解答:淋巴细胞
该细胞胞体、胞核均较大,胞质也较多但不呈深蓝色(只是边缘较深蓝),所以我个人认为还是归淋巴细胞较好,可能它是受应刺激后出现了一些变化,但还够不上异淋,不过在异淋较多的涂片中可考虑归异淋
异淋与受刺激淋巴细胞的划分界限不清,所以每个人的理解也不同
彩图129 解答:异淋
大家应该已经逐步掌握了异淋的一些主要特征了
彩图154 解答:异淋
该细胞还是一个核,只不过呈哑铃形而已,也不是浆细胞
浆细胞的胞质可以与它相似,但胞核应更小、更致密且常圆形
至于单核细胞,其胞质很不像,胞核也无折叠,只是染色质较疏松
彩图157 解答:(大)淋巴细胞
其胞质有裙边样结构并不代表是异淋,这样的淋巴细胞在一般血涂片中还是比较常见,不要归异淋哦
彩图173 解答:异型淋巴细胞(